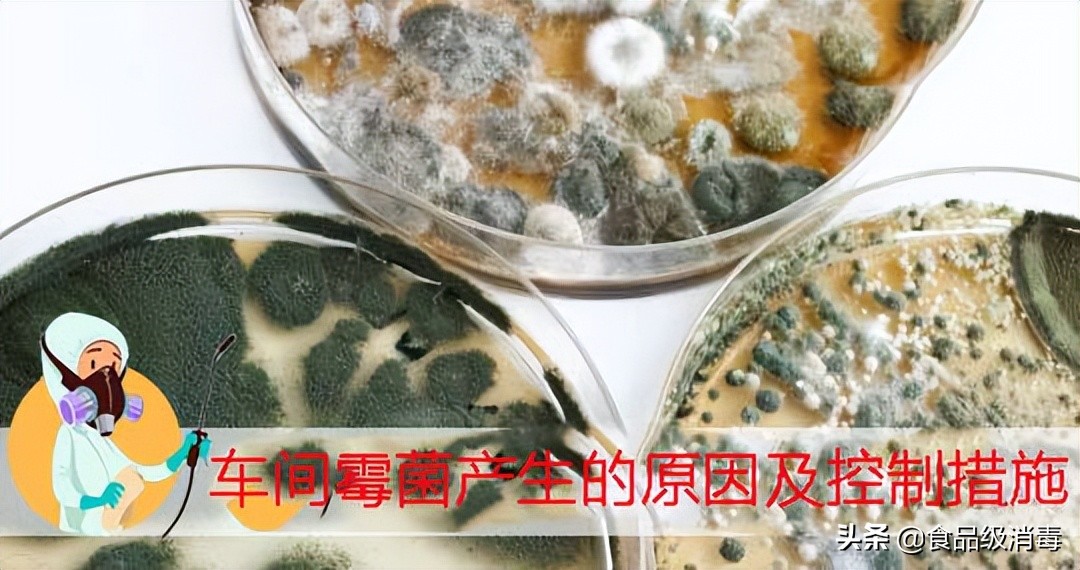
食品厂霉菌及孢子如何杀灭,季铵盐能不能杀灭霉菌孢子

关键词:车间霉菌 食品霉菌污染 霉菌消毒剂
霉菌是丝状真菌的总称,它们往往能形成分枝繁茂的菌丝体,在潮湿温暖的地方,经常会看到它。肉眼可见的绒毛状、絮状或蛛网状的菌落,那就是霉菌。霉菌有着极强的繁殖能力,而且繁殖方式也是多种多样的。
车间霉菌产生的原因及措施
烘焙食品加工企业在生产过程中,霉菌是最主要的微污染源之一。生产车间的霉菌如果不加以控制则会产生非常严重的后果,霉菌在温暖潮湿的环境中生长非常迅速,并且霉菌的孢子特别轻,只要产生风压引起风的流动,就可以漂浮降落在加工食品中,导致食品被污染,引发食物保质期缩短、腐败、长毛、变质的后果。
那么如何清除生产车间里的霉菌呢?
1 温湿度控制
引发霉菌生长繁殖最主要的因素就是温度和高湿度,所以要先控制车间的温度和湿度,温度在24度以下,湿度在55%以下,过高的温湿度会促进霉菌的生长。必要时应装设有效的换气设施,班中每2小时用风机及时将含有大量水分的空气排出车间, 以防止室内温度过高、蒸汽凝结或异味等发生。
2加工车间卫生控制
要保持生产车间的内部工具的清洁和卫生,注意对一些卫生死角进行严格的卫生清理和保持,定期检查车间有无生长霉菌的地方,发现有类似情况,就进行彻底清理,不要等到都长出菌丝了再擦拭,随时注意操作的卫生与减少污染的可能性。
3 人员的消毒灭菌工作
人员的工作服、更衣室等,必须保持卫生清洁,定期进行过氧化氢杀菌,防止人为造成霉菌的交叉污染。
4 空气的消毒灭菌
加工车间和冷却车间空气中可能存在的霉菌孢子经过漂浮降落,导致加工食品发生霉变的风险,所以空气的消毒是尤为重要的。可使用干雾化的食品级过氧化氢进行生产车间空气的灭菌工作。
5 设备、工器具等消毒
加工设备及管道的清洗非常重要。加工设 备及管道在使用后会产生一些沉积物,如不及时、彻底地清洗,将直接会影响产品的质量。食品级过氧化氢消毒是制造食品时防止霉菌与细菌污染最佳的方法,定期对加工设备,工具,管道进行喷洒,可有效杀灭霉菌。
对于食品厂生产车间霉菌的控制,很多企业因长时间、大剂量的通过臭氧或者紫外灯来控制车间霉菌的,对车间的设施造成老化和人员影响很大。并且消毒灭菌有一定的局限性,紫外线对霉菌孢子的杀菌效果有限。因此,选择一款可以长期、稳定、有效、无毒、无残留的消毒产品来控制车间霉菌,对于任何一个食品加工企业都很重要。而目前食品灭菌领域最先进的就是采用食品级过氧化氢进行灭菌工作,
奥克泰士为除霉菌剂具有很多优势,在痕量银离子的催化下,奥克泰士具有极高效的消毒杀菌作用,释放的羟基自由基的氧化能力还可以降解霉菌产生的大部分毒素,例如黄曲霉毒素对羟基自由基非常敏感。

车间灭菌剂
另外,霉菌孢子可以漂浮在空气中,在其中可以发现有过敏原性表面蛋白,也会被从过氧化氢分离出来的羟基自由基所变性和消除。使用奥克泰士 T-010处理霉菌时,霉菌产生孢子的能力被破坏,意味着当使用T-010时,空气中霉菌孢子的问题要少得多。这种作用是葡萄干加工车间十分需要的,因为使用奥克泰士进行预消毒就可以消除葡萄干加工过程中环境、空气和设备接触面对葡萄干造成二次污染。
优势总结:
- 高效,能够在较低浓度下抑制菌丝生长和孢子萌发,能够有效杀灭霉菌。
- 广谱,除了能够杀灭霉菌外,还可以杀灭细菌、真菌、病毒等所有类型微生物。
- 洁净生态,作用完毕后分解为水和氧气,没有毒性和残留。
- 不影响葡萄干外观、色泽,不破坏营养成分,不影响口感。
- 食品级,符合国家食品安全卫生标准,严格按照食品消毒剂标准检测认证。
- 德国品质,适于高标准要求企业及出口食品使用。
- 消除二次污染,多用途,可用于食品原料接触杀菌,车间环境空间消毒,食品接触面等各环节消毒。
- 可批量化处理,满足规模化生产需求。